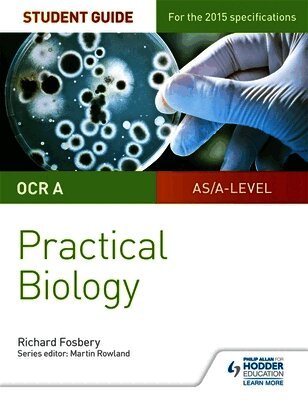

Richard Fosbery – författare
Visar alla böcker från författaren Richard Fosbery. Handla med fri frakt och snabb leverans.
17 produkter
17 produkter
516 kr
Skickas inom 5-8 vardagar
Human and Social Biology for CSEC 2nd Edition ® has been updated and tailored to support those studying the Human and Social Biology for CSEC syllabus. The course has been designed to allow students to work individually and co-operatively, using theoretical concepts in practical activities. In this way, students have every opportunity to apply investigative and problem-solving skills.
E-bok
PDF, Engelska554 kr
Läs direkt efter köp
Fully revised and updated content matching the Cambridge International AS & A Level Biology syllabus (9700). The PDF ebook of the fourth edition of the AS and A Level Biology coursebook comprehensively covers all the knowledge and skills students need to acquire during this CIE course. Written by renowned and leading experts in Biology teaching, the ebook is easy to navigate with colour-coded sections and clear signposting throughout. Self assessment questions allow learners to track their progression through the course and exam-style questions at the end of every chapter provide opportunity for learners to prepare thoroughly for their examinations. Contemporary contexts and applications are discussed throughout enhancing the relevance and interest for learners.
E-bok
Engelska, 2020549 kr
Läs direkt efter köp
For first examination from 2022, these resources meet the real needs of the biology classroom. Extensive research through lesson observations, teacher interviews and work with our research community (the Cambridge Panel) means that this eBook meets the real teaching needs of the biology classroom. Exam-style questions ensure students feel confident approaching assessment. New features provide reflection opportunities and self-evaluation checklists develop responsible learners. The coursebook provides a range of enquiry questions, such as practical activities, group work and debate questions that develop 21st century skills. It supports English as a second language learners with key command terms, accessible language and glossary definitions.
972 kr
Skickas inom 7-10 vardagar
Extensive research through lesson observations, teacher interviews and work with our research community (the Cambridge Panel) means that this coursebook with digital access meets the real teaching needs of the biology classroom. Exam-style questions ensure students feel confident approaching assessment. New features provide reflection opportunities and self-evaluation checklists develop responsible learners. The coursebook provides a range of enquiry questions, such as practical activities, group work and debate questions that develop 21st century skills. It supports English as a second language learners with key command terms, accessible language and glossary definitions.
E-bok
Engelska, 2014549 kr
Läs direkt efter köp
Fully revised and updated content matching the Cambridge International AS & A Level Biology syllabus (9700). Endorsed by Cambridge International Examinations, this digital edition comprehensively covers all the knowledge and skills students need during the A Level Biology course (9700), for first examination in 2016, in a reflowable format, adapting to any screen size or device. Written by renowned experts in Biology teaching, the text is written in an accessible style with international learners in mind. Self-assessment questions allow learners to track their progress, and exam-style questions help learners to prepare thoroughly for their examinations. Answers to all the questions from within the Coursebook are provided.
479 kr
Skickas inom 5-8 vardagar
The Cambridge International AS & A Level Biology Exam Success Guide brings clarity and focus to exam preparation, with detailed and practical guidance on raising attainment. The guide helps students to recap content through easy-to-digest chunks, apply knowledge with targeted revision activities, review and reflect on work done and raise their grades with sample answers, examiner commentary and exam-style practice.The Cambridge International AS & A Level Biology Exam Success Guide is written by Richard Fosbery, an examiner, teacher and teacher trainer, and students can benefit from his expertise and experience in what they need to help them succeed in their exams. Other resources include a Student Book which offers a rigorous yet accessible approach for covering the whole syllabus and an Enhanced Online Student Book which provides extra digital hotspots including downloadable questions and additional activities. These are also available in a great-value Print & Enhanced Online Student Book Pack.
2021
732 kr
Skickas inom 5-8 vardagar
The Cambridge IGCSE® & O Level Essential Biology Print and Enhanced Online Student Book Pack is at the heart of delivering the course and provides a clear, step-by-step route though the syllabus that is ideal for EAL learners. It has been fully matched to the latest Cambridge IGCSE (0610) and O Level (5090) Biology syllabuses, ensuring it covers everything students need to succeed. The pack contains a Print Student Book and an Enhanced Online Student Book, accessible in the classroom and at home. It offers support for class and homework, exam preparation, and assessment throughout the course with opportunities to grow understanding of scientific concepts and language. The Enhanced Online Student Book provides access to digital resources including interactive tests, practice papers, and worksheets.It is written by the experienced authors of our previous edition, Gareth Williams and Richard Fosbery, a Cambridge examiner. It has been reviewed by subject experts globally to ensure it meets teachers' needs.The licence period for the Online Student Book is 30 months from the date you activate the access code. The Student Book is also available in print or online only. The supporting Exam Success Guide and Practical Workbook help students achieve top exam marks, while the Workbook, for independent practice, strengthens exam potential.
591 kr
Skickas inom 5-8 vardagar
The Cambridge IGCSE® & O Level Essential Biology Student Book is at the heart of delivering the course and provides a clear, step-by-step route though the syllabus that is ideal for EAL learners. It has been fully updated and matched to the latest Cambridge IGCSE (0610) & O Level (5090) Biology syllabuses.The book uses an engaging and exam-focused approach that is accessible to all abilities, with varied and flexible assessment support and exam-style questions that improve students' performance and ensure every learner reaches their full potential. It combines depth of subject matter and clarity of material with concise, well-presented content, and includes embedded language for EAL students.The Student Book is written by the experienced author team of our previous edition, Gareth Williams and Richard Fosbery, a Cambridge examiner. It has also been reviewed by subject experts globally to help meet teachers' needs.The Student Book is available in print, online or via a great-value print and online pack. The supporting Exam Success Guide and Practical Workbook help students achieve top marks in their exams, while the Workbook, for independent practice, strengthens exam potential inside and outside the classroom.
E-bok
PDF, Engelska, 2021434 kr
Läs direkt efter köp
The Cambridge IGCSE® & O Level Essential Biology Student Book is at the heart of delivering the course and provides a clear, step-by-step route though the syllabus that is ideal for EAL learners. It has been fully updated and matched to the latest Cambridge IGCSE (0610) & O Level (5090) Biology syllabuses.The book uses an engaging and exam-focused approach that is accessible to all abilities, with varied and flexible assessment support and exam-style questions that improve students'' performance and ensure every learner reaches their full potential. It combines depth of subject matter and clarity of material with concise, well-presented content, and includes embedded language for EAL students.The Student Book is written by the experienced author team of our previous edition, Gareth Williams and Richard Fosbery, a Cambridge examiner. It has also been reviewed by subject experts globally to help meet teachers'' needs.The Student Book is available in print, online or via a great-value print and online pack. The supporting Exam Success Guide and Practical Workbook help students achieve top marks in their exams, while the Workbook, for independent practice, strengthens exam potential inside and outside the classroom.
E-bok
PDF, Engelska, 2021343 kr
Läs direkt efter köp
The Cambridge International AS & A Level Biology Exam Success Guide brings clarity and focus to exam preparation, with detailed and practical guidance on raising attainment.The guide helps students to recap content through easy-to-digest chunks, apply knowledge with targeted revision activities, review and reflect on work done and raise their grades with sample answers, examiner commentary and exam-style practice.The Cambridge International AS & A Level Biology Exam Success Guide is written by Richard Fosbery, an examiner, teacher and teacher trainer, and students can benefit from his expertise and experience in what they need to help them succeed in their exams.Other resources include a Student Book which offers a rigorous yet accessible approach for covering the whole syllabus and an Enhanced Online Student Book which provides extra digital hotspots including downloadable questions and additional activities. These are also available in a great-value Print & Enhanced Online Student Book Pack.
447 kr
Skickas inom 5-8 vardagar
For CXC students who want to prepare fully for their exams, CXC Study Guides are a series of titles that provide students with additional support to pass the exam. CXC Study Guides are a unique product that have been written by experienced examiners at CXC and carry the board's exclusive branding.
447 kr
Skickas inom 5-8 vardagar
For CXC students who want to prepare fully for their exams, CXC Study Guides are a series of titles that provide students with additional support to pass the exam. CXC Study Guides are a unique product that have been written by experienced examiners at CXC and carry the board's exclusive branding.
363 kr
Skickas inom 5-8 vardagar
These Study Guides have been developed exclusively with the Caribbean Examinations Council (CXC®) to be used as an additional resource by candidates who are following the Caribbean Secondary Education Certificate (CSEC®) programme. They provide candidates with extra support to help them maximise their performance in their examinations.
363 kr
Skickas inom 5-8 vardagar
These Study Guides have been developed exclusively with the Caribbean Examinations Council (CXC®) to be used as an additional resource by candidates who are following the Caribbean Secondary Education Certificate (CSEC®) programme. They provide candidates with extra support to help them maximise their performance in their examinations.
Häftad, Engelska, 2015
510 kr
Skickas inom 5-8 vardagar
Exam Board: OCRLevel: A-levelSubject: BiologyFirst Teaching: September 2015First Exam: June 2016This is an OCR endorsed resourceEncourage students to learn independently and build on their knowledge with this textbook that leads students seamlessly from basic biological concepts to more complicated theories.- Develop experimental, analytical and evaluation skills with activities that introduce the practicals required by OCR and other experimental investigations in Biology- Provide assessment guidance with synoptic questions and multiple choice questions throughout the book, and revision tips and skills all in one chapter- Strengthen understanding of key concepts with contemporary and engaging examples, illustrated with accessible diagrams and images - Give students the opportunity to apply their knowledge and understanding of all aspects of practical work with Test Yourself Questions and Exam Practice Questions- Offer detailed guidance and examples of method with a dedicated 'Maths in Biology' chapter and mathematical support throughout- Develop understanding with free online access to answers, an extended glossary, learning outcomes and topic summariesOCR A Level Biology Student Book 1 includes AS Level
Häftad, Engelska, 2016
517 kr
Skickas inom 10-15 vardagar
Exam Board: OCRLevel: A-levelSubject: BiologyFirst Teaching: September 2015First Exam: June 2016Encourage students to learn independently and build on their knowledge with this textbook that leads students seamlessly from basic biological concepts to more complicated theories.- Develop experimental, analytical and evaluation skills with activities that introduce the practicals required by OCR and other experimental investigations in Biology- Provide assessment guidance with synoptic questions and multiple choice questions throughout the book, and revision tips and skills all in one chapter- Strengthen understanding of key concepts with contemporary and engaging examples, illustrated with accessible diagrams and images- Give students the opportunity to apply their knowledge and understanding of all aspects of practical work with Test Yourself Questions and Exam Practice Questions- Offer detailed guidance and examples of method with a dedicated 'Maths in Biology' chapter and mathematical support throughout- Develop understanding with free online access to answers, an extended glossary, learning outcomes and topic summaries
Häftad, Engelska, 2017
163 kr
Skickas inom 5-8 vardagar
Exam Board: OCRLevel: AS/A-levelSubject: EconomicsFirst Teaching: September 2015First Exam: Summer 2016Ensure your students get to grips with the core practicals and develop the skills needed to succeed with an in-depth assessment-driven approach that builds and reinforces understanding; clear summaries of practical work with sample questions and answers help to improve exam technique in order to achieve higher grades.Written by experienced teacher Martin Rowland, this Student Guide for practical Biology:- Help students easily identify what they need to know with a concise summary of required practical work examined in the A-level specifications.- Consolidate understanding of practical work, methodology, mathematical and other skills out of the laboratory with exam tips and knowledge check questions, with answers in the back of the book.- Provide plenty of opportunities for students to improve exam technique with sample answers, examiners tips and exam-style questions. - Offer support beyond the Student books with coverage of methodologies and generic practical skills not focused on in the textbooks.